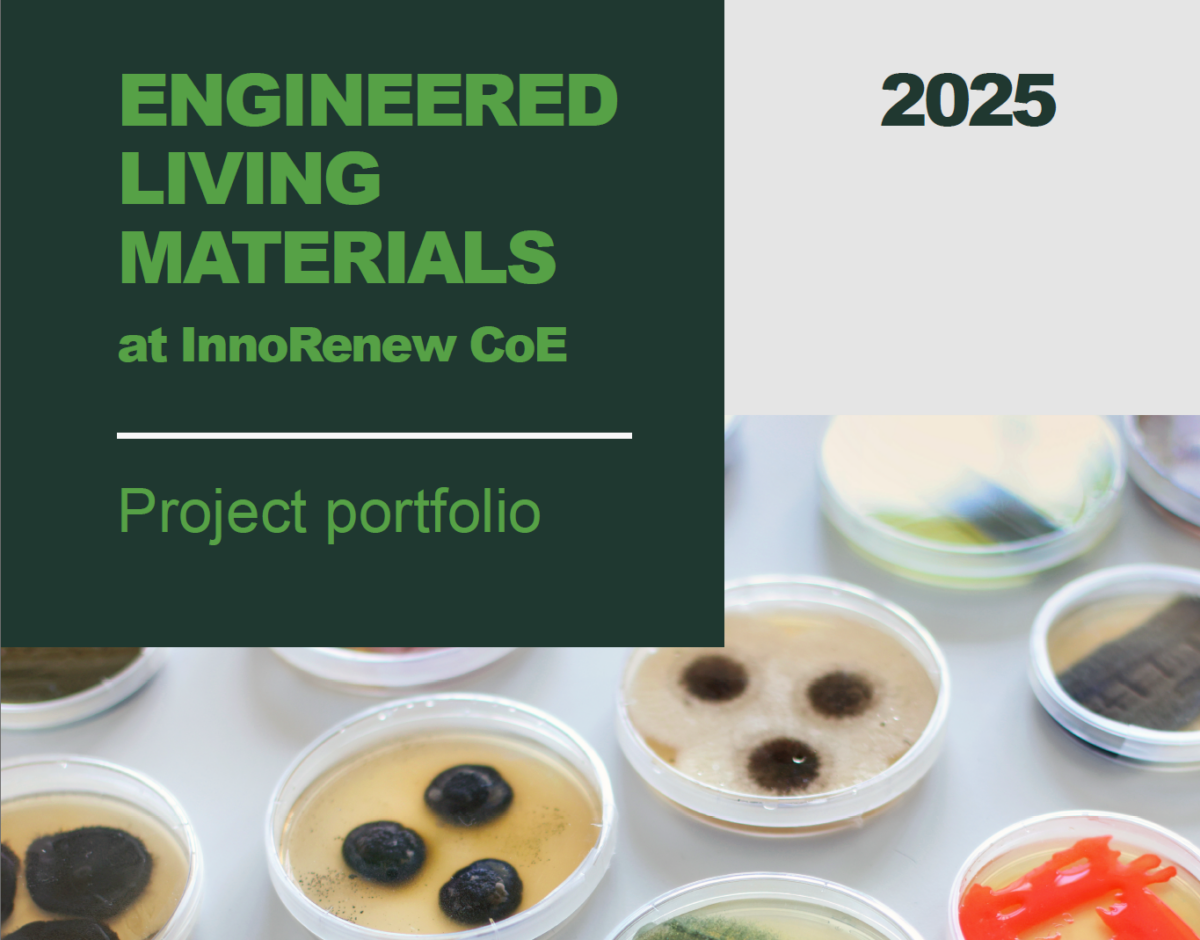

The REMEDY project contributes to the rapidly growing field engineered Living Materials (ELMs), supporting the development of sustainable, adaptive, and health-responsive building solutions. As part of a broader European effort to integrate biology and architecture, REMEDY works alongside related initiatives at InnoRenew CoE and across the EIC Pathfinder community.
A newly released ELM Research Line brochure presents how EMEDY connects with other ELM-related projects and initiatives developed at InnoRenew CoE, forming a coherent research vision that bridges materials science, biotechnology, and architectural innovation. The document illustrates ongoing progress towards regenerative, pollution-resilient, and circular construction systems.
This synergy exemplifies the interdisciplinary foundation of REMEDY — combining scientific excellence with real-world environmental impact.
Download the ELM Research Line brochure here – https://zenodo.org/records/17106693